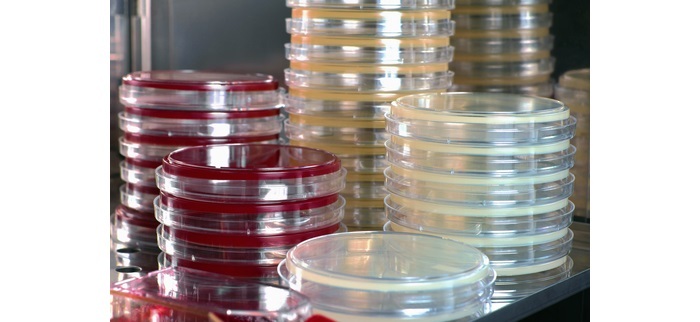
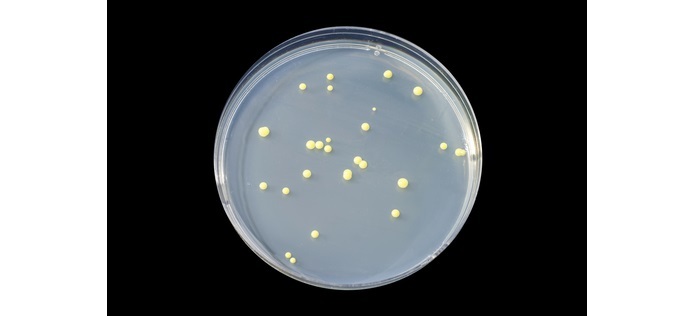
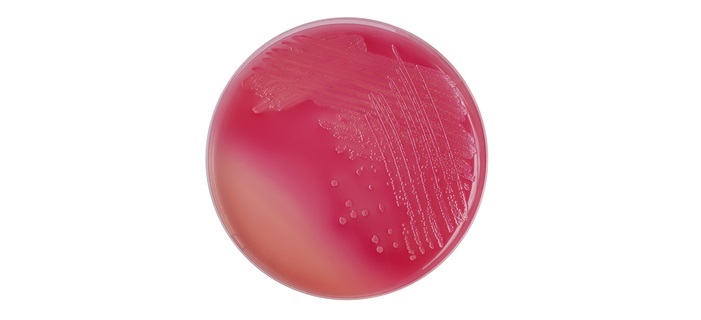

營養培養基及其製備
簡介
營養培養基是一種常用在微生物學中培養和生長各種微生物的生長培養基。它是由多種營養物質組成的複雜混合物,這些營養物質是細菌、酵母菌和真菌等微生物生長所必需的。
它可以使用各種不同的成分製成,每種成分都有其促進微生物生長的特定作用。下面將討論不同型別的營養培養基及其製備方法。
營養培養基的型別
微生物學中使用的營養培養基種類繁多,每種培養基都旨在滿足微生物生長的特定要求。一些最常用的營養培養基型別包括:
胰蛋白腖大豆瓊脂 (TSA)
胰蛋白腖大豆瓊脂 (TSA) 是一種通用的培養基,常用在微生物學中。它含有胰蛋白腖、大豆蛋白腖和瓊脂的混合物,為多種微生物的生長提供了豐富的營養來源。
血液瓊脂
血液瓊脂是一種含有綿羊血或馬血的營養培養基。血液為苛養型微生物的生長提供了營養來源,苛養型微生物是指需要特定生長條件才能生長的微生物。
麥康凱瓊脂
麥康凱瓊脂是一種選擇性培養基,常用於分離革蘭氏陰性菌。它含有膽鹽、結晶紫和乳糖,抑制革蘭氏陽性菌的生長,並選擇性地促進革蘭氏陰性菌的生長。
沙氏瓊脂
沙氏瓊脂是一種選擇性培養基,常用於分離真菌。它具有低pH值,抑制大多數細菌的生長,並促進真菌的生長。
營養培養基的成分
營養培養基的成分會因所用培養基的具體型別而異。然而,大多數型別的營養培養基中都有一些常見的成分,包括:
蛋白腖:蛋白腖是氨基酸和短肽的混合物,為微生物的生長提供氮和碳的來源。
牛肉膏:牛肉膏是牛肉的水溶性提取物,提供微生物生長所需的維生素、礦物質和其他營養物質。
瓊脂:瓊脂是一種用於使營養培養基凝固的膠凝劑。它來源於海藻,廣泛用於微生物學,因為它在高溫下穩定且不會隨著時間推移而降解。
氯化鈉:氯化鈉新增到營養培養基中,提供微生物生長所需的離子來源。
乳糖:乳糖是一種糖類,常用於選擇性培養基中,選擇性地促進特定微生物的生長。
製備營養培養基
製備營養培養基是微生物學中的一個關鍵步驟,因為它直接影響微生物的生長。製備營養培養基的過程會因所用培養基的具體型別而異,但通常包括以下步驟:
稱量和測量
製備營養培養基的第一步是稱量必要的成分。這通常包括稱量各種粉末並測量出適當體積的水。
混合和加熱
一旦成分被稱量出來,它們就會在燒瓶或燒杯中混合在一起。然後加熱混合物以溶解粉末並滅菌培養基。
滅菌
滅菌是製備營養培養基的關鍵步驟,因為它確保培養基不含任何可能干擾微生物生長的汙染物。可以使用幾種滅菌方法,包括高壓滅菌、過濾和輻照。
高壓滅菌是最常用的滅菌方法,它涉及將培養基在高溫(通常約為121°C)下加熱特定時間(通常約為15-20分鐘)。這可以殺死培養基中存在的任何微生物,並確保培養基是無菌的。

過濾也可用於滅菌營養培養基,特別是對於不能高壓滅菌的培養基。在這種方法中,培養基透過具有小孔的過濾器,可以截留培養基中存在的任何微生物。
輻照是另一種滅菌方法,它涉及將培養基暴露於伽馬射線。這種方法比高壓滅菌或過濾使用得少,但對某些型別的培養基很有用。
傾倒和冷卻
一旦培養基被滅菌,它就被倒入培養皿或試管中,並使其冷卻和凝固。這創造了一個微生物可以生長的固體表面。
接種
營養培養基製備和凝固後,可以使用微生物對其進行接種。這通常使用無菌環或針進行,用於將少量微生物轉移到培養基表面。

培養
一旦微生物接種到營養培養基上,培養皿或試管就被放入培養箱中,培養箱提供微生物生長的適當溫度和條件。培養時間會因所培養的微生物型別和所用營養培養基而異。
結論
營養培養基是微生物學中的一個關鍵組成部分,它為微生物的生長和研究提供了必要的營養物質和環境。營養培養基的具體成分和製備方法會因所用培養基的型別和所培養的微生物而異。
然而,仔細製備和滅菌營養培養基對於確保微生物實驗結果的準確性和可靠性至關重要。
資料結構
網路
關係資料庫管理系統 (RDBMS)
作業系統
Java
iOS
HTML
CSS
Android
Python
C語言程式設計
C++
C#
MongoDB
MySQL
Javascript
PHP